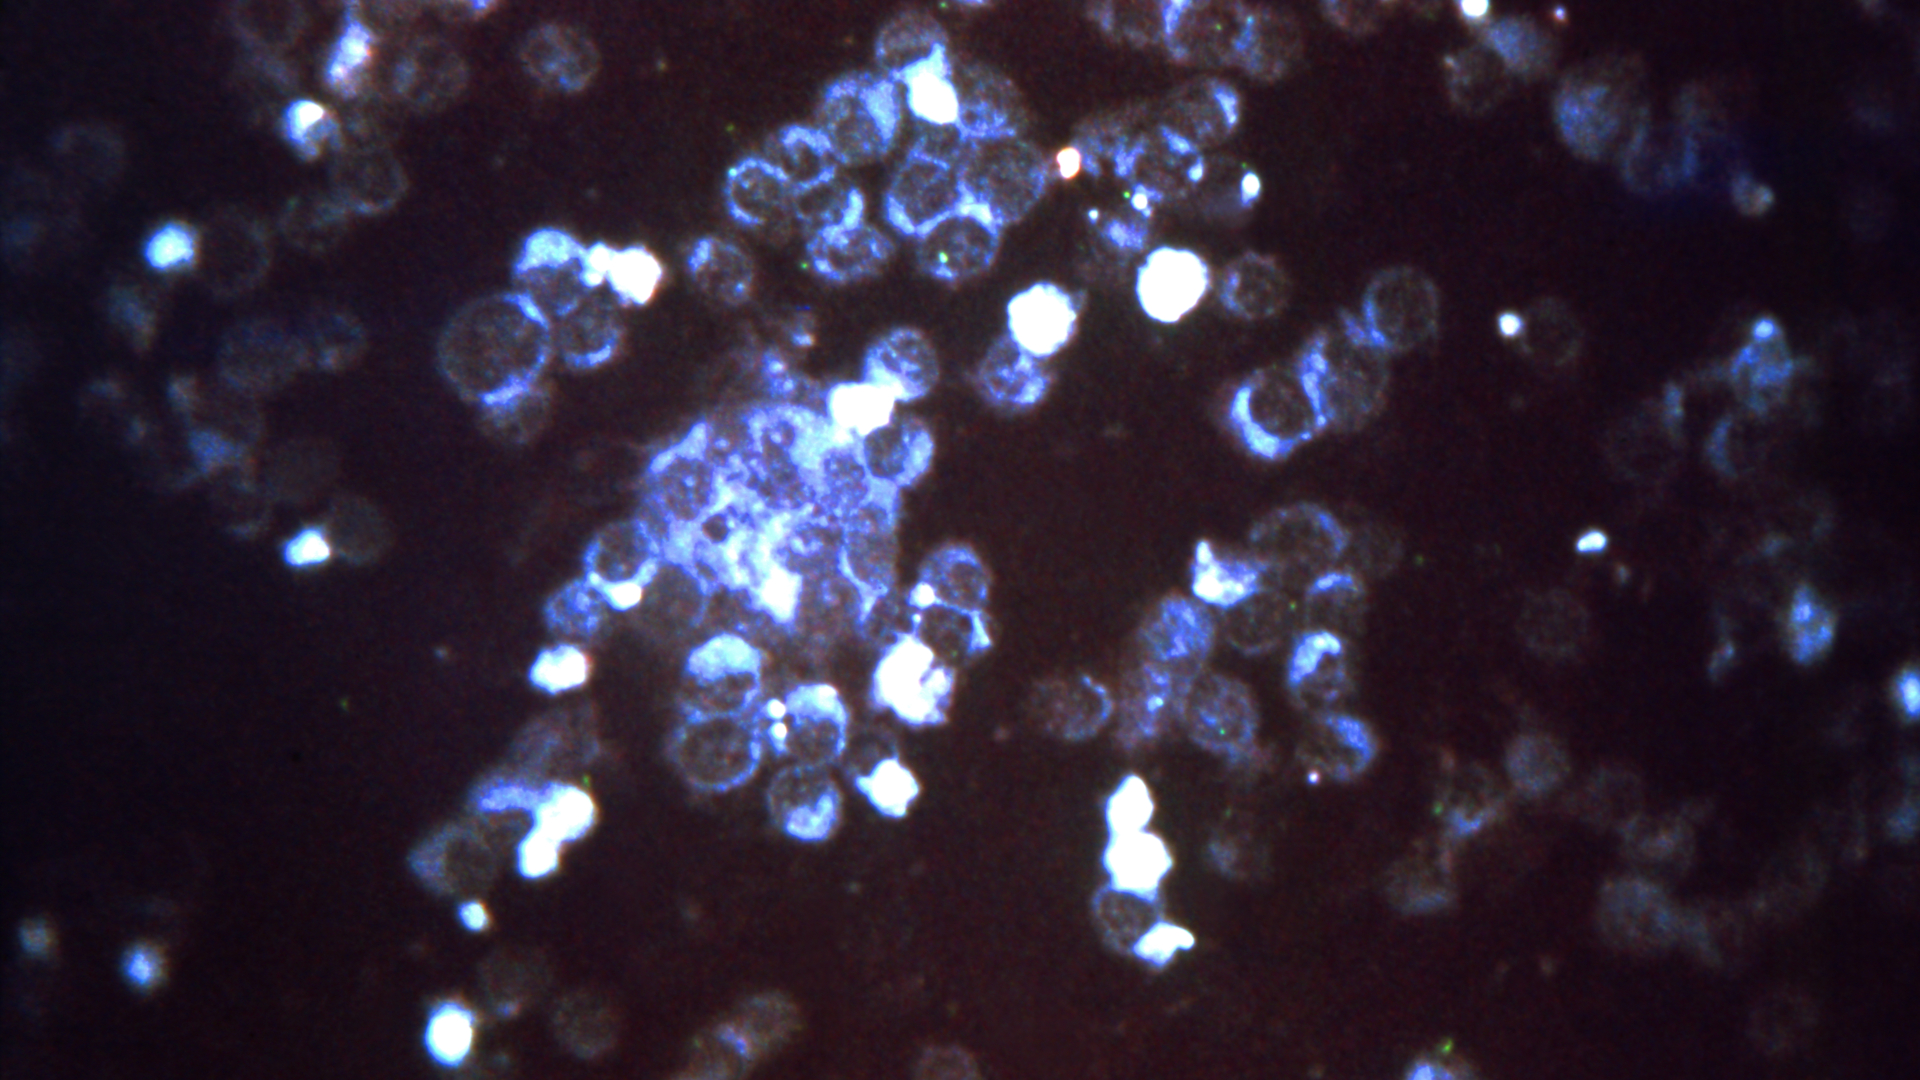
Courtesy of CDC

Moderna initiates phase 3 portion of pivotal trial for MRNA RSV vaccine candidate
Moderna, Inc., announced that the Data and Safety Monitoring Board (DSMB) for the RSV program has endorsed the start of the Phase 3 portion of the pivotal clinical study of mRNA-1345, the Company's Respiratory Syncytial Virus (RSV) vaccine candidate, in adults 60 years and older.
The DSMB's endorsement comes after independent review of preliminary Phase 2 data, which suggest that the vaccine has an acceptable safety profile in older adults at the selected dose. This study is known as ConquerRSV.
"RSV is one of the most widespread respiratory viruses, causing severe disease and hospitalization in older adults, and yet there is no vaccine available on the market," said Stéphane Bancel, Chief Executive Officer of Moderna. "We believe that our vaccine candidate against RSV has the potential to protect against over 1 million infections globally each year, improving quality of life for those at high-risk of becoming infected and reducing the burden on health care systems. An mRNA vaccine against RSV could have a positive impact on individuals, communities, and global public health. Our ultimate goal is to combine our RSV vaccine with our COVID-19 and flu boosters into a single dose booster."
RSV is a common respiratory virus that generally causes cold-like symptoms. While most people who contract RSV recover in approximately one to two weeks, the virus can be serious for young children and older adults. For these higher-risk groups, RSV is a leading cause of severe respiratory illness, including pneumonia and respiratory distress.
The burden of illness caused by RSV is substantial; each year in the United States, RSV causes approximately 177,000 hospitalizations and 14,000 deaths in adults 65 and older, resulting in an estimated $3 billion in annual medical costs.
RSV tends to be a seasonal illness, with infections in the United States and countries with similar climates primarily occurring during fall, winter and spring. In the past year, however, the COVID-19 pandemic has impacted normal transmission patterns, leading to unusual levels of infection.
In June 2021, the Centers for Disease Control and Prevention (CDC) issued a health alert flagging increased interseasonal RSV infection in certain parts of the United States, and similar trends have been seen globally. There is currently no approved vaccine for RSV.
mRNA-1345 is a vaccine against RSV encoding for a prefusion F glycoprotein, which elicits a higher neutralizing antibody response compared to the postfusion state. mRNA-1345 uses the same lipid nanoparticle (LNP) as Moderna's COVID-19 vaccine and contains optimized protein and codon sequences.
The FDA has granted Fast Track designation for mRNA-1345 in adults older than 60 years of age. The primary purpose of the Phase 3 segment of the study is to establish the safety and efficacy of mRNA-1345 vaccine in adults older than 60 years of age in support of licensure. Moderna expects to enroll approximately 34,000 participants.
Moderna is advancing mRNA vaccines against additional respiratory viruses including COVID-19 booster vaccine candidates and a seasonal flu vaccine candidate (mRNA-1010). The Company also recently announced that it is developing a single dose vaccine that combines a booster against COVID-19 and a booster against flu. In preclinical studies, Moderna has observed that its seasonal flu, RSV and COVID-19 booster vaccines can be combined into one dose that produces an immune response to all six antigens. Moderna intends to explore vaccine combinations including RSV, flu and COVID-19.